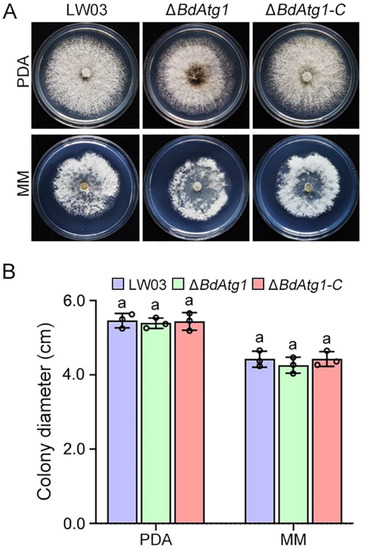

Abstract
Botryosphaeria canker and fruit rot caused by the fungus Botryosphaeria dothidea is one of the most destructive diseases of apple worldwide. Autophagy is an evolutionarily conserved self-degradation process that is important for maintaining homeostasis to ensure cellular functionality. To date, the role of autophagy in B. dothidea is not well elucidated. In this study, we identified and characterized the autophagy-related protein Atg1 in B. dothidea. The BdAtg1 deletion mutant ΔBdAtg1 showed autophagy blockade and phenotypic defects in mycelial growth, conidiation, ascosporulation and virulence. In addition, ΔBdAtg1 exhibited an increased number of nuclei in the mycelial compartment. Comparative transcriptome analysis revealed that inactivation of BdAtg1 significantly influenced multiple metabolic pathways. Taken together, our results indicate that BdAtg1 plays an important role in vegetative differentiation and the pathogenicity of B. dothidea. The results of this study will provide a reference for the development of new target-based fungicides.
1. Introduction
Botryosphaeria canker and fruit ring rot caused by the ascomycetous fungus Botryosphaeria dothidea (anamorph Dothiorella gregaria) is one of the most devastating diseases of apple worldwide [1,2]. The pathogen can infect both branches and fruits, and can occur in both pre- and post-harvesting phases, causing huge losses to apple production [3]. Currently, almost all apple varieties are susceptible to B. dothidea, and chemical control is still the most effective disease control strategy [4]. However, with the long-term and frequent application of chemical agents, B. dothidea populations have developed resistance to some fungicides [5]. Therefore, exploring the molecular mechanisms underlying development and virulence will contribute to disease resistance breeding and novel fungicide development, establishing a more efficient disease management strategy.
Over the past two decades, autophagy has attracted considerable attention as a conserved self-digestion process that is essential for the maintenance of cellular metabolism and energy homeostasis in eukaryotes [6,7]. The process of autophagy consists of several sequential steps: initiation, elongation, maturation, fusion and degradation, which was tightly regulated by a series of key components, including the family of autophagy-related genes (ATG) [8,9]. The Atg1/ULK1 plays a central role in the initiation of autophagy process: receiving signals of nutritional status, recruiting downstream Atg proteins to the autophagosome formation site, and governing the formation of autophagosome [10,11,12].
Studies on biological functions in eukaryotes from yeast to mammals have shown that Atg1 plays important roles in cellular development and differentiation [13]. Atg1 has been reported to be involved in mycelial growth, asexual and sexual reproduction, stress tolerance, secondary metabolism and pathogenicity in filamentous fungi such as Magnaporthe oryzae, Botrytis cinerea and Fusarium graminearum [14,15,16]. Despite the knowledge of autophagy and Atg1 in some fungi, the specific role of Atg1 in B. dothidea remains unknown until now. In this study, we identified and characterized BdAtg1 in B. dothidea, and determined its role in autophagy, fungal development and virulence.
2. Materials and Methods
2.1. Fungal Strains and Culture Conditions
The wild-type strain LW03 and mutants of B. dothidea were cultured on potato dextrose agar (PDA, 200 g potato, 20 g dextrose, 10 g agar and 1 L H2O) and minimal medium (MM, 0.5 g KCl, 2 g NaNO3, 1 g KH2PO4, 0.5 g MgSO4·7H2O, 0.01 g FeSO4·7H2O, 30 g sucrose, 200 μL trace element, 15 g agar and 1 L ddH2O, pH = 6.9) at 25 °C for mycelial growth test. Carrot agar medium (200 g carrot, 15 g agar and 1 L ddH2O) was used for conidial production. One-year-old branches of ‘Fuji’ apple were used for perithecial formation. Mycelia used for protein extraction were grown in yeast extract peptone dextrose medium (YEPD, 10 g peptone, 3 g yeast extract, 20 g dextrose and 1 L ddH2O, pH = 6.7) or MM-N (MM without nitrogen source).
2.2. Gene Deletion and Complementation
The BdATG1 deletion constructs were generated using a double-joint PCR approach [17]. Targeted deletion of BdATG1 was conducted based on a homologous recombination strategy (Figure S1A). The putative deletion mutants with hygromycin resistance (100 µg/mL) were preliminarily screened by PCR amplification and further identified by Southern blot hybridization analysis.
For complementation, the fragment containing the full-length of BdATG1 and native promoter was inserted into PYF11 vector and transformed into the BdATG1 deletion mutant. The expression of BdATG1 in a complemented strain was detected by Western blotting assay. Protoplast preparation and transformation were performed as described previously [18].
2.3. Staining and Microscopy
The fresh mycelia of B. dothidea were stained with CMAC (7-amino-4-chloromethylcoumarin) and BODIPY (dipyrrometheneboron difluoride) to observe vacuoles and lipid droplets, respectively. Microscopic examination was performed using a Leica TCS SP5 confocal laser scanning microscope (Leica, Wetzlar, Germany).
2.4. Protein Manipulation and Western Blotting
Mycelia for protein extraction were grown in a liquid medium at 25 °C with 180-rpm rotation. The total protein was extracted from mycelia as described previously [19]. A monoclonal anti-GFP antibody (ab 32146, Abcam, Cambridge, MA, USA) and an anti-glyceraldehyde-3-phosphate dehydrogenase (GAPDH) antibody (EM1101, Hangzhou Huaan Biotechnology Co., Ltd., Hangzhou, China) were used for immunoblot analyses. These experiments were repeated three times independently.
2.5. Pathogenicity Tests
Pathogenicity of B. dothidea was determined by inoculating detached fruits, branches and leaves of ‘Fuji’ apple. Briefly, the samples were wounded and inoculated with agar plugs of actively growing mycelia. Agar plugs without mycelia were used as a negative control. The inoculated samples were placed at 25 °C under high relative humidity (~95%) conditions. The disease lesions developed on inoculated samples were measured and photographed at 7 days post-inoculation. These experiments were repeated three times with 10 replicates in each repeat experiment.
2.6. Transcriptome Sequencing and Analysis
Total RNA was isolated using Trizol reagent (Takara Inc., Dalian, China), according to the manufacturer’s instructions. The sequencing libraries were generated using NEBNext UltraTM RNA Library Prep Kit for Illumina (NEB, Ipswich, MA, USA), following the manufacturer’s recommendations. The clustering of the index-coded samples was performed on a cBot Cluster Generation System using TruSeq Cluster Kit v3-cBot-HS (Illumia, Bologna, Italy), according to the manufacturer’s instructions. The library preparations were sequenced on an Illumina Nova platform and 150 bp paired-end reads were generated. Differential expression analysis was performed using DESeq2 R package (1.16.1). The ClusterProfiler R package was used to perform the statistical enrichment of differential expression genes in KEGG pathways and Gene Ontology (GO).
3. Results
3.1. Identification of BdATG1 in B. dothidea
To obtain the Atg1 encoding gene in B. dothidea, the protein sequence of Atg1 from Saccharomyces cerevisiae was used to perform a BLASTp search in the genome database of B. dothidea (https://www.ncbi.nlm.nih.gov/biosample/SAMN13735646, accessed on 19, March, 2020). BdATG1 is 3049 bp in length with 2 introns, and is predicted to encode a protein of 966 amino acids which shares 47.09% identity with S. cerevisiae Atg1. Phylogenetic analysis revealed that BdAtg1 shared a close ancestor with Atg1 of M. oryzae (Figure 1A). Sequence alignment revealed that the serine/threonine kinase domain of Atg1 is evolutionarily conserved among B. dothidea, S. cerevisiae and H. sapiens (Figure 1B).

Figure 1.
Evolutionary analysis of BdAtg1. (A) Phylogenetic tree of BdAtg1 and other orthologs from fungi, including Fusarium graminearum, Verticillium dahliae, Neurospora crassa, Sordaria macrospora, Botrytis cinerea, Aspergillus niger, Magnaporthe oryzae and Saccharomyces cerevisiae. (B) Sequence alignment of serine-threonine kinase domains form B. dothidea, S. cerevisiae and Humo sapiens. The green overlines indicate the serine-threonine kinase domain and the red asterisks indicate ATP-binding sites.
3.2. Deletion and Complementation of BdATG1 in B. dothidea
To investigate the biological functions of BdATG1, we generated BdATG1 deletion mutants by using a homologous recombination strategy (Figure S1A). The putative transformants were first screened by PCR amplification (Figure S1B) with diagnostic primers (Table S1), and further identified by southern blot analysis (Figure S1C). To complement the BdATG1 deletion mutant, the full-length BdATG1 (under native promoter) was transformed into ΔBdAtg1, and the expression of BdATG1 was detected by Western blotting assay (Figure S1D).
3.3. BdAtg1 Is Indispensable for Autophagy
GFP-Atg8 is a useable marker to monitor autophagy process [20]. To clarify the effect of BdAtg1 on autophagy, we examined the occurrence of autophagy in LW03 and ΔBdAtg1. As shown in Figure 2A, the GFP-BdAtg8 signals of LW03 transferred to vacuoles under nitrogen-lacking conditions, however, no GFP-BdAtg8 signals were observed in the vacuoles of ΔBdAtg1. In addition, the proteolysis of GFP-BdAtg8 was analyzed. The protein levels of full-length GFP-BdAtg8 were significantly decreased in LW03 but not in ΔBdAtg1 under nitrogen-lacking conditions (Figure 2B,C). These results indicate that BaAtg1 is essential for autophagy in B. dothidea.

Figure 2.
BdAtg1 is indispensable for autophagy. (A) GFP-BdAtg8 localization in the mycelia of the wild-type strain LW03 and BdATG1 deletion mutant ΔBdAtg1 under the conditions of sufficient or lack of nitrogen source. (B) GFP-BdAtg8 proteolysis of each strain (starvation for 0 and 8 h) was detected by Western blotting using anti-GFP antibody. GAPDH was used as an internal reference. (C) The percentage of GFP on the total of GFP and GFP-BdAtg8. Error bars indicate standard deviation from three independent experiments. Values on the bars followed by the same letter are not significantly different at p = 0.05.
3.4. BdAtg1 Is Involved in Vegetative Growth
To determine the role of BdAtg1 in mycelial growth, the wild-type strain LW03, BdATG1 deletion mutant ΔBdAtg1 and the complemented strain ΔBdAtg1-C were cultured on PDA and MM media. Compared with LW03 and ΔBdAtg1-C, the amount of aerial mycelium in ΔBdAtg1 was significantly reduced (Figure 3A), but the growth rate showed no significant change (Figure 3B). These results indicate that BdAtg1 is involved in vegetative growth in B. dothidea.
Figure 3.
BdAtg1 is involved in mycelial growth. (A) Strains of B. dothidea were grown on PDA and MM media at 25 °C for 3 days. (B) Mycelial growth rate of each strain on PDA and MM media. Error bars indicate standard deviation from three independent experiments. Values on the bars followed by the same letter are not significantly different at p = 0.05.
3.5. BdAtg1 Is Crucial for Asexual and Sexual Reproduction
To determine the role of BdAtg1 in conidiation, each strain was cultured on carrot agar medium. After 7 days of incubation with black light exposure at 25 °C, LW03 and ΔBdAtg1-C produced many fruiting bodies containing conidia, while ΔBdAtg1 produced fewer fruiting bodies containing malformed conidia (Figure 4A,B). The average length of the conidia of ΔBdAtg1 was significantly lower than that of LW03 and ΔBdAtg1-C (Figure 4C), and the conidia germination of ΔBdAtg1 was delayed (Figure 4D). In addition, a significant decrease of lipid droplets was observed in ΔBdAtg1 compared to LW03 and ΔBdAtg1-C (Figure 4E).

Figure 4.
BdAtg1 is crucial for conidiation. (A) Fruiting bodies formed on carrot agar medium by B. dothidea strains (upper panel), and conidial morphology of each strain (bottom panel). The red arrows in indicate fruiting bodies. (B) Number of fruiting bodies formed by each strain. (C) Average length of conidia of each strain. (D) Conidia germination rete of each strain. Error bars indicate standard deviation from three independent experiments. Values on the bars followed by the same letter are not significantly different at p = 0.05. (E) Lipid droplets within conidia of each strain.
To determine the role of BdAtg1 in ascosporulation, each strain was inoculated to one-year-old apple branches. After 30 days of incubation at room temperature with intermittent water spray, ΔBdAtg1 failed to form ascus, while LW03 and ΔBdAtg1-C formed many asci containing ascospores (Figure 5). These results indicate that BdAtg1 plays an important role in asexual and sexual reproduction.

Figure 5.
BdAtg1 is essential for ascosporulation. (A) Perithecia formed on apple branches by B. dothidea strains. The red arrows indicate asci. (B) Ascus and ascospores produced by each strain.
3.6. BdAtg1 Is Required for Full Virulence
To determine the role of BdAtg1 in virulence, each strain was inoculated to young apple fruits, one-year-old branches and leaves. After 7 days of moisturizing incubation at 25 °C, the disease lesions caused by ΔBdAtg1 were slightly smaller than that of LW03 and ΔBdAtg1-C (Figure 6A). Notably, ΔBdAtg1 almost lost the ability to infect branches and leaves, while LW03 and ΔBdAtg1-C caused severe disease symptoms (Figure 6B–D). These results indicate that BdAtg1 plays a crucial role in plant infection in B. dothidea.

Figure 6.
BdAtg1 is required for virulence. Disease symptoms on apple fruits (A), branches (B) and leaves (C) following inoculation with B. dothidea strains for 7 days. (D) Lesion size on apple fruits, branches and leaves caused by each strain. Error bars indicate standard deviation from three independent experiments. Values on the bars followed by the same letter are not significantly different at p = 0.05.
3.7. BdAtg1 Mediates Nuclei Distribution
Autophagy has been reported to contribute to the regulation of nuclear dynamics in the filamentous fungus Fusarium oxysporum [21]. To test the effect of BdAtg1 on nuclear dynamic in B. dothidea, the nuclei in mycelial compartments of each strain was observed. As shown in Figure 7, the number of nuclei per mycelial compartment in LW03 and ΔBdAtg1-C was mostly 2 to 4, while the number of nuclei in ΔBdAtg1 was mostly 4 to 8. These results indicate that BdAtg1 regulates nuclear dynamics in B. dothidea.

Figure 7.
BdAtg1 mediates nuclei distribution. (A) Nuclei distribution in mycelia of B. dothidea strains. (B) The number of nuclei in mycelial compartment of each strain.
3.8. BdAtg1 Influences Multiple Metabolic Pathways
Because of the number of severe phenotypic changes, we performed a transcriptome sequencing of LW03 and ΔBdAtg1 during the mycelial growth stage. Compared with LW03, a total of 760 differentially expressed genes (DEGs) were identified in ΔBdAtg1, including 561 and 199 upregulated and downregulated genes, respectively (Figure S2). Gene Ontology (GO) and KEGG enrichment analysis revealed that inactivation of BdAtg1 significantly affected multiple metabolic pathways in B. dothidea (Figure 8). These results suggest that BdAtg1 regulates multiple metabolic pathways in B. dothidea.

Figure 8.
BdAtg1 influences multiple metabolic pathways. (A) Comparative Gene Ontology (GO) analysis of the differentially expressed genes (DEGs) between the transcriptome of LW03 and ΔBdAtg1. (B) Comparative KEGG pathways analysis of the DEGs between the transcriptome of LW03 and ΔBdAtg1.
4. Discussion
Autophagy is a catabolic process that maintains cellular homeostasis to ensure normal life activities in eukaryotes [22]. Recently, autophagy has been shown to play an important role in the growth, development and virulence in filamentous fungi [23,24]. In this study, we identified and characterized the autophagy protein Atg1 in B. dothidea. Phylogenetic tree and functional domain alignment suggested that BdAtg1 is evolutionarily conserved in eukaryotes. In addition, the deletion of BdATG1 blocked the autophagy process in B. dothidea, which is consistent with that of S. cerevisiae and other filamentous fungi [25,26].
The endogenous recycling of intracellular components mediated by autophagy is crucial for material and energy supply during fungal vegetative growth and development [27]. In this study, the mycelial growth rate of ΔBdAtg1 remained unchanged, but the amount of aerial mycelium was significantly reduced on media plates, which is consistent with the role of Atg1 in aerial mycelium growth in other filamentous fungi, such as M. oryzae, B. cinerea and F. graminearum [14,15,16]. In addition, ΔBdAtg1 produced fewer conidia with malformation, displayed delayed conidial germination, and failed to form ascus, which is similar to the role of Atg1 in asexual and sexual reproduction in most filamentous fungi [23].
The infection process of pathogenic fungi requires autophagic degradation to meet the excessive demands for material and energy during this period [28]. Like other pathogenic fungi [29], the ability of ΔBdAtg1 to infect apple fruits, branches and leaves was significantly reduced. Notably, ΔBdAtg1 caused disease lesions on apple fruits, while almost losing the ability to infect branches and leaves. These findings suggest that BdAtg1 plays an important role in the infection process of B. dothidea.
To date, the biological function of autophagy has not been fully recognized in filamentous fungi. In this study, we analyzed the gene expression profiles through comparative transcriptome. The results revealed that the expression of many genes belonging to multiple metabolic pathways were affected in ΔBdAtg1. These results demonstrate the involvement of autophagy in multiple metabolic pathways in B. dothidea.
5. Conclusions
In summary, our results indicate that the autophagy protein Atg1 plays an important role in mycelial growth, conidiation, ascosporulation and virulence, and is involved in multiple metabolic pathways.
Supplementary Materials
The following supporting information can be downloaded at: https://www.mdpi.com/article/10.3390/jof8090904/s1, Figure S1: Target deletion of BdATG1 in B. dothidea; Figure S2: Differentially expressed genes (DEGs) of transcriptome sequencing; Table S1: PCR primers used in this study.
Author Contributions
N.L., B.L. and W.R. designed this study; N.L., M.Z., Y.Z. and Z.W. performed experiments, analyzed all data, and wrote the initial manuscript, and all authors contributed to the writing and editing of the final manuscript. All authors have read and agreed to the published version of the manuscript.
Funding
This work was supported by the China Agriculture Research System (CARS-28) and the Scientific Research Fund for High-level Talents in Qingdao Agricultural University (665/1120060 and 663/1121023).
Institutional Review Board Statement
Not applicable.
Informed Consent Statement
Not applicable.
Data Availability Statement
All experimental data in this study will be made available upon reasonable request from readers.
Conflicts of Interest
The authors declare no conflict of interest.
References
- Dong, X.; Cheng, Z.; Leng, W.; Li, B.; Xu, X.; Lian, S.; Wang, C. Progression of symptoms caused by Botryosphaeria dothidea on apple branches. Phytopathology 2021, 111, 1551–1559. [Google Scholar] [CrossRef] [PubMed]
- Marsberg, A.; Kemler, M.; Jami, F.; Nagel, J.H.; Postma-Smidt, A.; Naidoo, S.; Wingfield, M.J.; Crous, P.W.; Spatafora, J.W.; Hesse, C.N.; et al. Botryosphaeria dothidea: A latent pathogen of global importance to woody plant health. Mol. Plant Pathol. 2017, 18, 477–488. [Google Scholar] [CrossRef] [PubMed]
- Huang, Y.; Sun, C.; Guan, X.; Lian, S.; Li, B.; Wang, C. Biocontrol efficiency of Meyerozyma guilliermondii Y-1 against apple postharvest decay caused by Botryosphaeria dothidea and the possible mechanisms of action. Int. J. Food Microbiol. 2021, 338, 108957. [Google Scholar] [CrossRef] [PubMed]
- Tang, W.; Ding, Z.; Zhou, Z.; Wang, Y.; Guo, L. Phylogenetic and pathogenic analyses show that the causal agent of apple ring rot in China is Botryosphaeria dothidea. Plant Dis. 2012, 96, 486–496. [Google Scholar] [CrossRef] [PubMed]
- Wang, L.; Tu, H.; Hou, H.; Zhou, Z.; Yuan, H.; Luo, C.; Gu, Q. Occurrence and detection of carbendazim resistance in Botryosphaeria dothidea from apple orchards in China. Plant Dis. 2022, 106, 207–214. [Google Scholar] [CrossRef]
- Boya, P.; Reggiori, F.; Codogno, P. Emerging regulation and functions of autophagy. Nat. Cell Biol. 2013, 15, 713–720. [Google Scholar] [CrossRef]
- Sedwick, C. Yoshinori Ohsumi: Autophagy from beginning to end. J. Cell Biol. 2012, 197, 164–165. [Google Scholar] [CrossRef]
- Jiang, G.; Tan, Y.; Wang, H.; Peng, L.; Chen, H.; Meng, X.; Li, L.; Liu, Y.; Li, W.; Shan, H. The relationship between autophagy and the immune system and its applications for tumor immunotherapy. Mol. Cancer 2019, 18, 17. [Google Scholar] [CrossRef]
- Mizushima, N. Autophagy: Process and function. Gene. Dev. 2007, 21, 2861–2873. [Google Scholar] [CrossRef]
- Chan, E.Y.; Tooze, S.A. Evolution of Atg1 function and regulation. Autophagy 2009, 5, 758–765. [Google Scholar] [CrossRef] [Green Version]
- Mizushima, N. The role of the Atg1/ULK1 complex in autophagy regulation. Curr. Opin. Cell Biol. 2010, 22, 132–139. [Google Scholar] [CrossRef]
- Noda, N.N.; Fujioka, Y. Atg1 family kinases in autophagy initiation. Cell. Mol. Life Sci. 2015, 72, 3083–3096. [Google Scholar] [CrossRef] [PubMed]
- Wang, B.; Kundu, M. Canonical and noncanonical functions of ULK/Atg1. Curr. Opin. Cell Biol. 2017, 45, 47–54. [Google Scholar] [CrossRef] [PubMed]
- Liu, X.; Lu, J.; Zhang, L.; Dong, B.; Min, H.; Lin, F. Involvement of a Magnaporthe grisea serine/threonine kinase gene, MgATG1, in appressorium turgor and pathogenesis. Eukaryot. Cell 2007, 6, 997–1005. [Google Scholar] [CrossRef] [PubMed]
- Ren, W.; Zhang, Z.; Shao, W.; Yang, Y.; Zhou, M.; Chen, C. The autophagy-related gene BcATG1 is involved in fungal development and pathogenesis in Botrytis cinerea. Mol. Plant Pathol. 2017, 18, 238–248. [Google Scholar] [CrossRef]
- Lv, W.; Wang, C.; Yang, N.; Que, Y.; Talbot, N.J.; Wang, Z. Genome-wide functional analysis reveals that autophagy is necessary for growth, sporulation, deoxynivalenol production and virulence in Fusarium graminearum. Sci. Rep. 2017, 7, 11062. [Google Scholar] [CrossRef]
- Yu, J.H.; Hamari, Z.; Han, K.H.; Seo, J.A.; Reyes-Domínguez, Y.; Scazzocchio, C. Double-joint PCR: A PCR-based molecular tool for gene manipulations in filamentous fungi. Fungal Genet. Biol. 2004, 41, 973–981. [Google Scholar] [CrossRef]
- Gronover, C.S.; Kasulke, D.; Tudzynski, P.; Tudzynski, B. The role of G protein alpha subunits in the infection process of the gray mold fungus Botrytis cinerea. Mol. Plant Microbe Interact. 2001, 14, 1293–1302. [Google Scholar] [CrossRef]
- Yu, F.; Gu, Q.; Yun, Y.; Yin, Y.; Xu, J.R.; Shim, W.B.; Ma, Z. The TOR signaling pathway regulates vegetative development and virulence in Fusarium graminearum. New phytol. 2014, 203, 219–232. [Google Scholar] [CrossRef]
- Nair, U.; Thumm, M.; Klionsky, D.J.; Krick, R. GFP-Atg8 protease protection as a tool to monitor autophagosome biogenesis. Autophagy 2011, 7, 1546–1550. [Google Scholar] [CrossRef] [Green Version]
- Corral-Ramos, C.; Roca, M.G.; Di Pietro, A.; Roncero, M.I.; Ruiz-Roldán, C. Autophagy contributes to regulation of nuclear dynamics during vegetative growth and hyphal fusion in Fusarium oxysporum. Autophagy 2015, 11, 131–144. [Google Scholar] [CrossRef] [PubMed]
- Chun, Y.; Kim, J. Autophagy: An essential degradation program for cellular homeostasis and life. Cells 2018, 7, 278. [Google Scholar] [CrossRef] [PubMed]
- Pollack, J.K.; Harris, S.D.; Marten, M.R. Autophagy in filamentous fungi. Fungal Genet. Biol. 2009, 46, 1–8. [Google Scholar] [CrossRef] [PubMed]
- Khan, I.A.; Lu, J.; Liu, X.; Rehman, A.; Lin, F. Multifunction of autophagy-related genes in filamentous fungi. Microbiol. Res. 2012, 167, 339–345. [Google Scholar] [CrossRef] [PubMed]
- Pan, Z.; Shao, G.; Liu, X.; Chen, Q.; Dong, M.; Du, L. Atg1 kinase in fission yeast is activated by Atg11-mediated dimerization and cis-autophosphorylation. eLife 2020, 9, e58073. [Google Scholar] [CrossRef]
- Yanagisawa, S.; Kikuma, T.; Kitamoto, K. Functional analysis of Aoatg1 and detection of the Cvt pathway in Aspergillus oryzae. FEMS Microbiol. Lett. 2013, 338, 168–176. [Google Scholar] [CrossRef]
- Shoji, J.; Arioka, M.; Kitamoto, K. Possible involvement of pleiomorphic vacuolar networks in nutrient recycling in filamentous fungi. Autophagy 2006, 2, 226–227. [Google Scholar] [CrossRef]
- Liu, X.; Gao, H.; Xu, F.; Lu, J.; Devenish, R.J.; Lin, F. Autophagy vitalizes the pathogenicity of pathogenic fungi. Autophagy 2012, 8, 1415–1425. [Google Scholar] [CrossRef]
- Zhu, X.; Li, L.; Wu, M.; Liang, S.; Shi, H.; Liu, X.; Lin, F. Current opinions on autophagy in pathogenicity of fungi. Virulence 2019, 10, 481–489. [Google Scholar] [CrossRef] [Green Version]
Publisher’s Note: MDPI stays neutral with regard to jurisdictional claims in published maps and institutional affiliations. |
© 2022 by the authors. Licensee MDPI, Basel, Switzerland. This article is an open access article distributed under the terms and conditions of the Creative Commons Attribution (CC BY) license (https://creativecommons.org/licenses/by/4.0/).